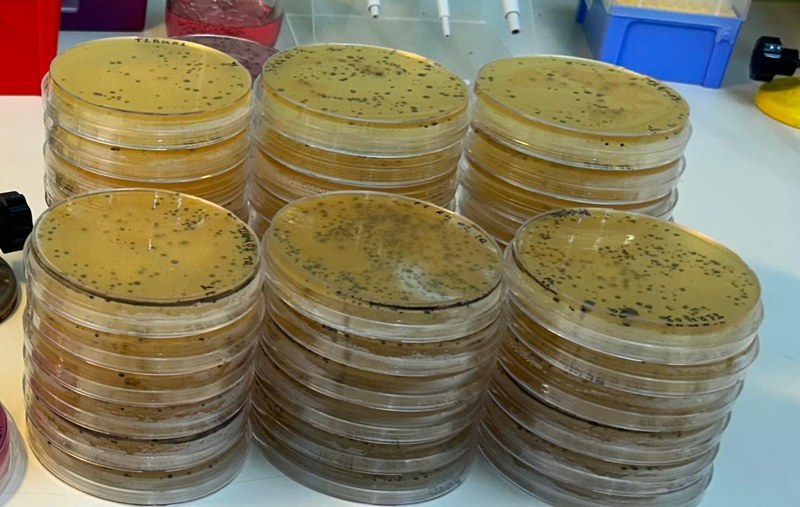

Videos and tutorials
🧀 pH Measurement of Cheese Samples for Laboratory Analysis
This video demonstrates measuring pH in cheese samples as part of a microbiology laboratory analysis.
🧀 Cheese Sample Preparation for Laboratory Analysis
This video shows the cutting and preparation of cheese samples for laboratory analysis. Proper sample preparation is an essential step to ensure that laboratory tests provide accurate and representative results.
🧀 Enumeration of Mesophilic Bacteria in Cheese Sample | Microbiology Laboratory Method
In this video, we demonstrate the enumeration of mesophilic bacteria in a cheese sample. Mesophilic bacteria grow optimally at moderate temperatures (approximately 30–37 °C), and their counts indicate the overall hygienic quality, processing conditions, and shelf life of cheese.
🧫MALDI-TOF Microbial Detection | Rapid Identification of Microorganisms
In this video, we demonstrate microbial identification using MALDI-TOF mass spectrometry, a rapid and accurate technique widely used in clinical, food, and environmental microbiology laboratories.
🧀 Enumeration of Staphylococcus aureus | Microbiological Analysis in Cheese Samples
In this video, we demonstrate the enumeration of Staphylococcus aureus, an important pathogenic bacterium commonly monitored in food microbiology and safety testing.